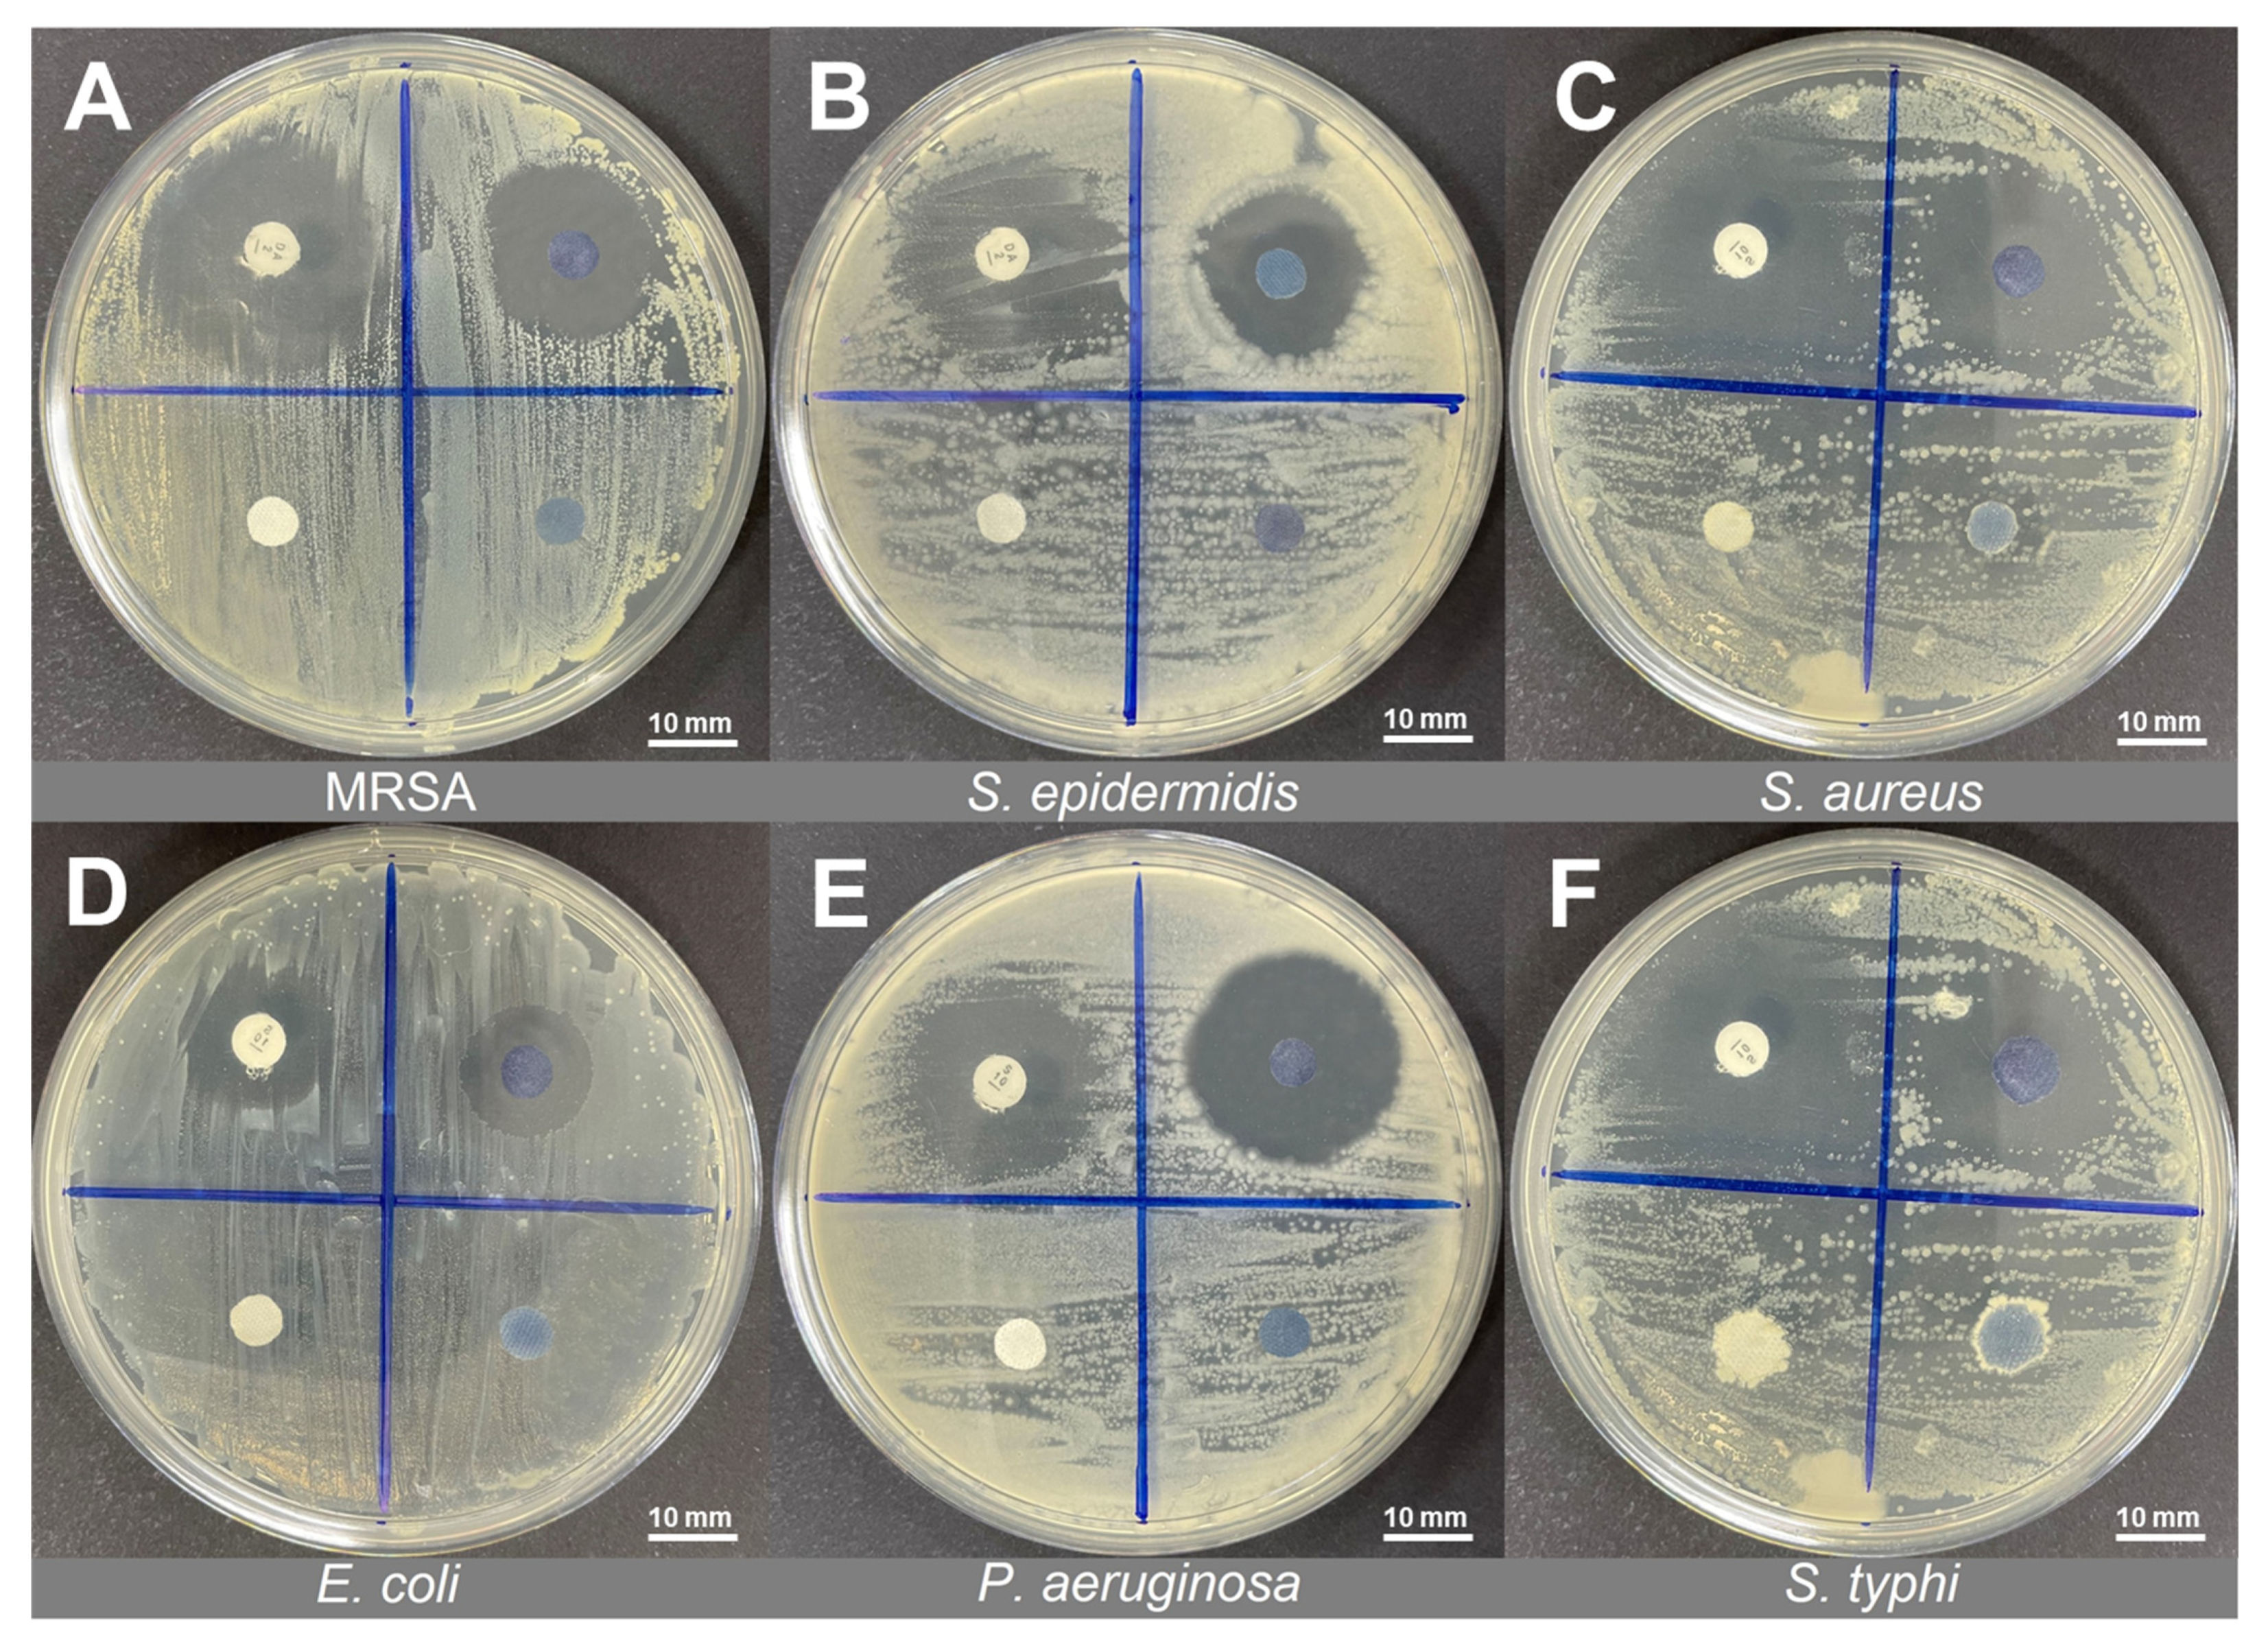

Antibacterial Performance of Protonated Polyaniline-Integrated Polyester Fabrics
Abstract
:1. Introduction
2. Materials and Methods
2.1. Materials
2.2. Preparation of Protonated PANI Fabric
2.3. DPPH Radical-Scavenging Assay
2.4. Statistical Analysis
2.5. Kirby–Bauer Disk Diffusion
2.6. Characterisation of Protonated PANI-Integrated Fabrics
2.6.1. Attenuated Total Reflectance–Fourier Transform Infrared (ATR–FTIR) Analysis in Collaboration with Energy Dispersive X–ray Fluorescence (EDXRF) Spectroscopy
2.6.2. Electrochemical Impedance Spectroscopy (EIS)
2.6.3. Scanning Electron Microscopy (SEM) Analysis
2.6.4. Thermogravimetric Analysis (TGA)
3. Results and Discussion
3.1. Fabrication of PANI Fabrics
3.2. Antioxidant Activity of PANI Fabrics
3.3. Antibacterial Performance of PANI Fabrics
3.4. Morphological Characterization of Bacteria Strains
3.5. Structural Confirmation and Elemental Identification of Treated PANI Fabric
3.6. Conductivity Measurement of Protonated PANI Fabric
3.7. Thermal Stability of PANI Fabric
4. Conclusions
Author Contributions
Funding
Institutional Review Board Statement
Informed Consent Statement
Data Availability Statement
Acknowledgments
Conflicts of Interest
References
- Gao, S.; Su, J.; Wang, W.; Fu, J.; Wang, H. Highly Efficient and Durable Antibacterial Cotton Fabrics Finished with Zwitterionic Polysulfobetaine by One-Step Eco-Friendly Strategy. Cellulose 2021, 28, 1139–1152. [Google Scholar] [CrossRef] [PubMed]
- Ayub, A.N.; Ismail, N.A.; Aizamddin, M.F.; Bonnia, N.N.; Sulaiman, N.S.; Nadzri, N.I.M.; Mahat, M.M. Effects of Organic Solvent Doping on the Structural and Conductivity Properties of PEDOT: PSS Fabric. J. Phys. Conf. Ser. 2022, 2169, 012008. [Google Scholar] [CrossRef]
- Karim, N.; Afroj, S.; Lloyd, K.; Oaten, L.C.; Andreeva, D.V.; Carr, C.; Farmery, A.D.; Kim, I.D.; Novoselov, K.S. Sustainable Personal Protective Clothing for Healthcare Applications: A Review. ACS Nano 2020, 14, 12313–12340. [Google Scholar] [CrossRef] [PubMed]
- Adlhart, C.; Verran, J.; Azevedo, N.F.; Olmez, H.; Keinänen-Toivola, M.M.; Gouveia, I.; Melo, L.F.; Crijns, F. Surface Modifications for Antimicrobial Effects in the Healthcare Setting: A Critical Overview. J. Hosp. Infect. 2018, 99, 239–249. [Google Scholar] [CrossRef] [PubMed] [Green Version]
- Balasubramaniam, B.; Prateek; Ranjan, S.; Saraf, M.; Kar, P.; Singh, S.P.; Thakur, V.K.; Singh, A.; Gupta, R.K. Antibacterial and Antiviral Functional Materials: Chemistry and Biological Activity toward Tackling COVID-19-like Pandemics. ACS Pharmacol. Transl. Sci. 2021, 4, 8–54. [Google Scholar] [CrossRef] [PubMed]
- Slavin, Y.N.; Asnis, J.; Häfeli, U.O.; Bach, H. Metal Nanoparticles: Understanding the Mechanisms behind Antibacterial Activity. J. Nanobiotechnol. 2017, 15, 65. [Google Scholar] [CrossRef]
- Sui, L.; Zhang, B.; Wang, J.; Cai, A. Polymerization of PEDOT/PSS/Chitosan-Coated Electrodes for Electrochemical Bio-Sensing. Coatings 2017, 7, 96. [Google Scholar] [CrossRef] [Green Version]
- Ishida, T. Antibacterial Mechanism of Ag+ Ions for Bacteriolyses of Bacterial Cell Walls via Peptidoglycan Autolysins, and DNA Damages. MOJ Toxicol. 2018, 4, 345–350. [Google Scholar] [CrossRef] [Green Version]
- Aizamddin, M.F.; Mahat, M.M.; Ariffin, Z.Z.; Samsudin, I.; Razali, M.S.M.; Amir, M.A. Synthesis, Characterisation and Antibacterial Properties of Silicone–Silver Thin Film for the Potential of Medical Device Applications. Polymers 2021, 13, 3822. [Google Scholar] [CrossRef]
- Mahat, M.M.; Sabere, A.S.M.; Azizi, J.; Amdan, N.A.N. Potential Applications of Conducting Polymers to Reduce Secondary Bacterial Infections among COVID-19 Patients: A Review. Emergent Mater. 2021, 4, 279–292. [Google Scholar] [CrossRef]
- Zafari, M.; Mansouri, M.; Omidghaemi, S.; Yazdani, A.; Pourmotabed, S.; Hasanpour Dehkordi, A.; Nosrati, H.; Validi, M.; Sharifi, E. Physical and Biological Properties of Blend-Electrospun Polycaprolactone/Chitosan-Based Wound Dressings Loaded with N-Decyl-N, N-Dimethyl-1-Decanaminium Chloride: An in Vitro and in Vivo Study. J. Biomed. Mater. Res. Part B Appl. Biomater. 2020, 108, 3084–3098. [Google Scholar] [CrossRef] [PubMed]
- Naradala, J. Antibacterial Activity of Copper Nanoparticles Synthesized by Bambusa Arundinacea Leaves Extract. Biointerface Res. Appl. Chem. 2021, 12, 1230–1236. [Google Scholar]
- Gudkov, S.V.; Burmistrov, D.E.; Serov, D.A.; Rebezov, M.B.; Semenova, A.A.; Lisitsyn, A.B. A Mini Review of Antibacterial Properties of ZnO Nanoparticles. Front. Phys. 2021, 9, 641481. [Google Scholar] [CrossRef]
- Sánchez-López, E.; Gomes, D.; Esteruelas, G.; Bonilla, L.; Lopez-Machado, A.L.; Galindo, R.; Cano, A.; Espina, M.; Ettcheto, M.; Camins, A.; et al. Metal-Based Nanoparticles as Antimicrobial Agents: An Overview. Nanomaterials 2020, 10, 292. [Google Scholar] [CrossRef] [Green Version]
- Aizamddin, M.F.; Mahat, M.M.; Nawawi, M.A. Morphological, Structural and Electrochemical Studies of Conductive Polyaniline Coated Polyester Fabrics. Int. Exc. Inn. Conf. Eng. Sci. 2019, 5, 53–57. [Google Scholar]
- Aizamddin, M.F.; Roslan, N.C.; Kamarudin, M.A.; Omar, S.N.I.; Safian, M.F.; Halim, M.I.A.; Mahat, M.M. Study of Conductivity and Thermal Properties of Polyaniline Doped with P-Toluene Sulfonic Acid. Malays. J. Anal. Sci. 2020, 24, 413–421. [Google Scholar]
- Roslan, N.C.; Aizamddin, M.F.; Omar, S.N.I.; Jani, N.A.; Halim, M.I.A.; Ariffin, Z.Z.; Mahat, M.M. Morphological and Conductivity Studies of Polyaniline Fabric Doped Phosphoric Acid. Malays. J. Anal. Sci. 2020, 24, 698–706. [Google Scholar]
- Mahat, M.M.; Mawad, D.; Nelson, G.W.; Fearn, S.; Palgrave, R.G.; Payne, D.J.; Stevens, M.M. Elucidating the Deprotonation of Polyaniline Films by X-Ray Photoelectron Spectroscopy. J. Mater. Chem. C 2015, 3, 7180–7186. [Google Scholar] [CrossRef]
- Dos Santos, M.R.; da Silva, F.A.G.; Ferrais, P.P.; de Lima, R.S.; da Costa, M.M.; de Oliveira, H.P. Polyaniline-Coated Calotropis Procera L. Hollow Tubular Fibers with Remarkable Antibacterial Activity. SN Appl. Sci. 2020, 2, 1550. [Google Scholar] [CrossRef]
- Robertson, J.; Gizdavic-Nikolaidis, M.; Nieuwoudt, M.K.; Swift, S. The Antimicrobial Action of Polyaniline Involves Production of Oxidative Stress While Functionalisation of Polyaniline Introduces Additional Mechanisms. PeerJ 2018, 2018, e5135. [Google Scholar] [CrossRef]
- Omar, S.N.I.; Zainal Ariffin, Z.; Zakaria, A.; Safian, M.F.; Halim, M.I.A.; Ramli, R.; Sofian, Z.M.; Zulkifli, M.F.; Aizamddin, M.F.; Mahat, M.M. Electrically Conductive Fabric Coated with Polyaniline: Physicochemical Characterisation and Antibacterial Assessment. Emergent Mater. 2020, 7, 469–477. [Google Scholar] [CrossRef]
- Jarach, N.; Meridor, D.; Buzhor, M.; Raichman, D.; Dodiuk, H.; Kenig, S.; Amir, E. Hybrid Antibacterial and Electro-Conductive Coating for Textiles Based on Cationic Conjugated Polymer. Polymers 2020, 12, 1517. [Google Scholar] [CrossRef] [PubMed]
- Maráková, N.; Humpolíček, P.; Kašpárková, V.; Capáková, Z.; Martinková, L.; Bober, P.; Trchová, M.; Stejskal, J. Antimicrobial Activity and Cytotoxicity of Cotton Fabric Coated with Conducting Polymers, Polyaniline or Polypyrrole, and with Deposited Silver Nanoparticles. Appl. Surf. Sci. 2017, 396, 169–176. [Google Scholar] [CrossRef]
- Falak, S.; Shin, B.K.; Huh, D.S. Antibacterial Activity of Polyaniline Coated in the Patterned Film Depending on the Surface Morphology and Acidic Dopant. Nanomaterials 2022, 12, 1085. [Google Scholar] [CrossRef]
- Maruthapandi, M.; Saravanan, A.; Luong, J.H.T.; Gedanken, A. Antimicrobial Properties of Polyaniline and Polypyrrole Decorated with Zinc-Doped Copper Oxide Microparticles. Polymers 2020, 12, 1286. [Google Scholar] [CrossRef]
- Bagheri, M.; Validi, M.; Gholipour, A.; Makvandi, P.; Sharifi, E. Chitosan Nanofiber Biocomposites for Potential Wound Healing Applications: Antioxidant Activity with Synergic Antibacterial Effect. Bioeng. Transl. Med. 2022, 7, e10254. [Google Scholar] [CrossRef]
- Saaid, F.I.; Tseung-Yuen, T.; Winie, T. PVdF-HFP Quasi-Solid-State Electrolyte for Application in Dye-Sensitized Solar Cells. Int. J. Technol. 2018, 9, 1187–1195. [Google Scholar] [CrossRef] [Green Version]
- Asri, N.A.N.; Amir, B.; Ramli, A.S.; Safian, M.F.; Zakaria, A.; Jani, N.A.; Mahat, M.M. The Effect of Ethylene Glycol Post-Treatment on the Electrical Conductivity of PEDOT: PSS Thin Films. J. Phys. Conf. Ser. 2022, 2169, 012036. [Google Scholar] [CrossRef]
- Ocampo, A.M.; Santos, L.R.; Julian, S.; Bailon, M.X.; Bautista, J. Polyaniline-Based Cadaverine Sensor through Digital Image Colorimetry. E Polym. 2018, 18, 465–471. [Google Scholar] [CrossRef]
- Karaoğlan, N.; Bindal, C. Synthesis and Optical Characterization of Benzene Sulfonic Acid Doped Polyaniline. Eng. Sci. Technol. Int. J. 2018, 21, 1152–1158. [Google Scholar] [CrossRef]
- Valadão de Faria, P.; Backes, E.H.; Montagna, L.S.; de Souza Pinto, S.; Pessan, L.A.; Rezende, M.C.; Passador, F.R. Effect of PANI on Thermal, Mechanical and Electromagnetic Properties of HDPE/LLDPE/PANI Composites. Mater. Res. 2018, 21, 1–9. [Google Scholar]
- Nassar, M.S.M.; Hazzah, W.A.; Bakr, W.M.K. Evaluation of Antibiotic Susceptibility Test Results: How Guilty a Laboratory Could Be? J. Egypt. Public Health Assoc. 2019, 94, 4. [Google Scholar] [CrossRef] [PubMed] [Green Version]
- Alam, J.; Shukla, A.K.; Ansari, M.A.; Ali, F.A.A.; Alhoshan, M. Dye Separation and Antibacterial Activities of Polyaniline Thin Film-Coated Poly(Phenyl Sulfone) Membranes. Membranes 2021, 11, 25. [Google Scholar] [CrossRef] [PubMed]
- Cuerda-correa, E.M.; Alexandre-franco, M.F.; Fern, C. Antibiotics from Water: An Overview. Water 2020, 12, 1–50. [Google Scholar]
- Rojas, E.R.; Billings, G.; Odermatt, P.D.; Auer, G.K.; Zhu, L.; Miguel, A.; Chang, F.; Weibel, D.B.; Theriot, J.A.; Huang, K.C.; et al. The Outer Membrane is an Essential Load-Bearing Element in Gram-Negative Bacteria. Nature 2018, 559, 617–621. [Google Scholar] [CrossRef]
- Ekande, O.S.; Kumar, M. Review on Polyaniline as Reductive Photocatalyst for the Construction of the Visible Light Active Heterojunction for the Generation of Reactive Oxygen Species. J. Environ. Chem. Eng. 2021, 9, 105725. [Google Scholar] [CrossRef]
- Bednarczyk, K.; Matysiak, W.; Tański, T.; Janeczek, H.; Schab-Balcerzak, E.; Libera, M. Effect of Polyaniline Content and Protonating Dopants on Electroconductive Composites. Sci. Rep. 2021, 11, 7487. [Google Scholar] [CrossRef]
- Butoi, B.; Groza, A.; Dinca, P.; Balan, A.; Barna, V. Morphological and Structural Analysis of Polyaniline and Poly(o-Anisidine) Layers Generated in a DC Glow Discharge Plasma by Using an Oblique Angle Electrode Deposition Configuration. Polymers 2017, 9, 732. [Google Scholar] [CrossRef] [Green Version]
- Omar, S.N.I.; Zainal Ariffin, Z.; Akhir, R.M.; Halim, M.I.A.; Ramli, R.; Mahat, M.M. Electrically Conductive Polyester Fabrics Embedded Polyaniline. Int. J. Eng. Technol. 2018, 7, 524–528. [Google Scholar] [CrossRef]
- Dhand, C.; Dwivedi, N.; Solanki, P.R.; Mayandi, V.; Beuerman, R.W.; Ramakrishna, S.; Lakshminarayanan, R.; Malhotra, B.D. Polyaniline-Based Biosensors. Nanobiosens. Dis. Diagn. 2015, 4, 25–46. [Google Scholar]
- Namsheer, K.; Rout, C.S. Conducting Polymers: A Comprehensive Review on Recent Advances in Synthesis, Properties and Applications. RSC Adv. 2021, 11, 5659–5697. [Google Scholar]
- Adila, D.; Ruzaidi, A.; Mahat, M.M.; Sofian, Z.M.; Adli, N.; Hashim, N.; Osman, H.; Nawawi, M.A.; Ramli, R.; Jantan, K.A.; et al. Synthesis and Characterization of Porous, Electro-Conductive Potential Use in Tissue Engineering. Polymers 2021, 13, 2901. [Google Scholar]
- Mashkour, M.; Rahimnejad, M.; Mashkour, M. Bacterial Cellulose-Polyaniline Nano-Biocomposite: A Porous Media Hydrogel Bioanode Enhancing the Performance of Microbial Fuel Cell. J. Power Sources 2016, 325, 322–328. [Google Scholar] [CrossRef]
- Mahat, M.M.; Aizamddin, M.F.; Roslan, N.C.; Kamarudin, M.A.; Nurzatul, S.; Omar, I.; Mazo, M.M. Conductivity, Morphology and Thermal Studies of Polyaniline Fabrics. Aust. J. Mech. Eng. 2020, 9, 137–150. [Google Scholar]
- Kundu, C.K.; Li, Z.; Song, L.; Hu, Y. An Overview of Fire Retardant Treatments for Synthetic Textiles: From Traditional Approaches to Recent Applications. Eur. Polym. J. 2020, 137, 109911. [Google Scholar] [CrossRef]

| Type of Bacteria | Antibiotic Disc (Control) | |
|---|---|---|
| Gram-positive | MRSA (BAA2094) | Clindamycin (DA—2 µg) |
| S. epidermidis (ATCC12228) | Clindamycin (DA—2 µg) | |
| S. aureus (ATCC25923) | Clindamycin (DA—2 µg) | |
| Gram-negative | E. coli (ATCC1129) | Streptomycin (S—10 µg) |
| P. aeruginosa (ATCC10145) | Streptomycin (S—10 µg) | |
| S. typhi (ATCC10428) | Streptomycin (S—10 µg) | |
| Fabric | Scavenging Activity (%) |
|---|---|
| Bare PES | NIL |
| Undoped PANI | 35.74 ± 1.01 |
| pTSA-doped PANI fabric | 84.83 ± 1.50 |
| Type of Bacteria | Antibiotic Disc (AB)—Control | Inhibition Zone (mm) of Protonated PANI Fabric with pTSA (DF) | |
|---|---|---|---|
| Gram-positive | MRSA (BAA2094) | Clindamycin (DA—2 µg) | 21.50 ± 0.09 |
| S. epidermidis (ATCC12228) | Clindamycin (DA—2 µg) | 19.11 ± 0.02 | |
| S. aureus (ATCC25923) | Clindamycin (DA—2 µg) | 22.30 ± 0.03 | |
| Gram-negative | E. coli (ATCC1129) | Streptomycin (S—10 µg) | 14.12 ± 0.07 |
| P. aeruginosa (ATCC10145) | Streptomycin (S—10 µg) | 24.33 ± 0.02 | |
| S. typhi (ATCC10428) | Streptomycin (S—10 µg) | 21.35 ± 0.08 | |
| Fabric | Elemental Composition (%) | |
|---|---|---|
| Nitrogen (N) | Sulfur (S) | |
| Untreated PANI | 46.17 ± 2.02 | 32.25 ± 2.01 |
| Treated with S. aureus | 32.88 ± 2.98 | 17.28 ± 1.96 |
| Treated with P. aeruginosa | 37.99 ± 1.72 | 18.31 ± 1.95 |
| Fabric | Conductivity (S cm−1) |
|---|---|
| Untreated PANI | 3.35 ± 6.66 × 10−3 |
| Treated with S. aureus | 4.58 ± 1.14 × 10−4 |
| Treated with P. aeruginosa | 6.19 ± 2.46 × 10−4 |
Publisher’s Note: MDPI stays neutral with regard to jurisdictional claims in published maps and institutional affiliations. |
© 2022 by the authors. Licensee MDPI, Basel, Switzerland. This article is an open access article distributed under the terms and conditions of the Creative Commons Attribution (CC BY) license (https://creativecommons.org/licenses/by/4.0/).
Share and Cite
Aizamddin, M.F.; Mahat, M.M.; Zainal Ariffin, Z.; Nawawi, M.A.; Jani, N.A.; Nor Amdan, N.A.; Sadasivuni, K.K. Antibacterial Performance of Protonated Polyaniline-Integrated Polyester Fabrics. Polymers 2022, 14, 2617. https://doi.org/10.3390/polym14132617
Aizamddin MF, Mahat MM, Zainal Ariffin Z, Nawawi MA, Jani NA, Nor Amdan NA, Sadasivuni KK. Antibacterial Performance of Protonated Polyaniline-Integrated Polyester Fabrics. Polymers. 2022; 14(13):2617. https://doi.org/10.3390/polym14132617
Chicago/Turabian StyleAizamddin, Muhammad Faiz, Mohd Muzamir Mahat, Zaidah Zainal Ariffin, Mohd Azizi Nawawi, Nur Aimi Jani, Nur Asyura Nor Amdan, and Kishor Kumar Sadasivuni. 2022. "Antibacterial Performance of Protonated Polyaniline-Integrated Polyester Fabrics" Polymers 14, no. 13: 2617. https://doi.org/10.3390/polym14132617
APA StyleAizamddin, M. F., Mahat, M. M., Zainal Ariffin, Z., Nawawi, M. A., Jani, N. A., Nor Amdan, N. A., & Sadasivuni, K. K. (2022). Antibacterial Performance of Protonated Polyaniline-Integrated Polyester Fabrics. Polymers, 14(13), 2617. https://doi.org/10.3390/polym14132617

